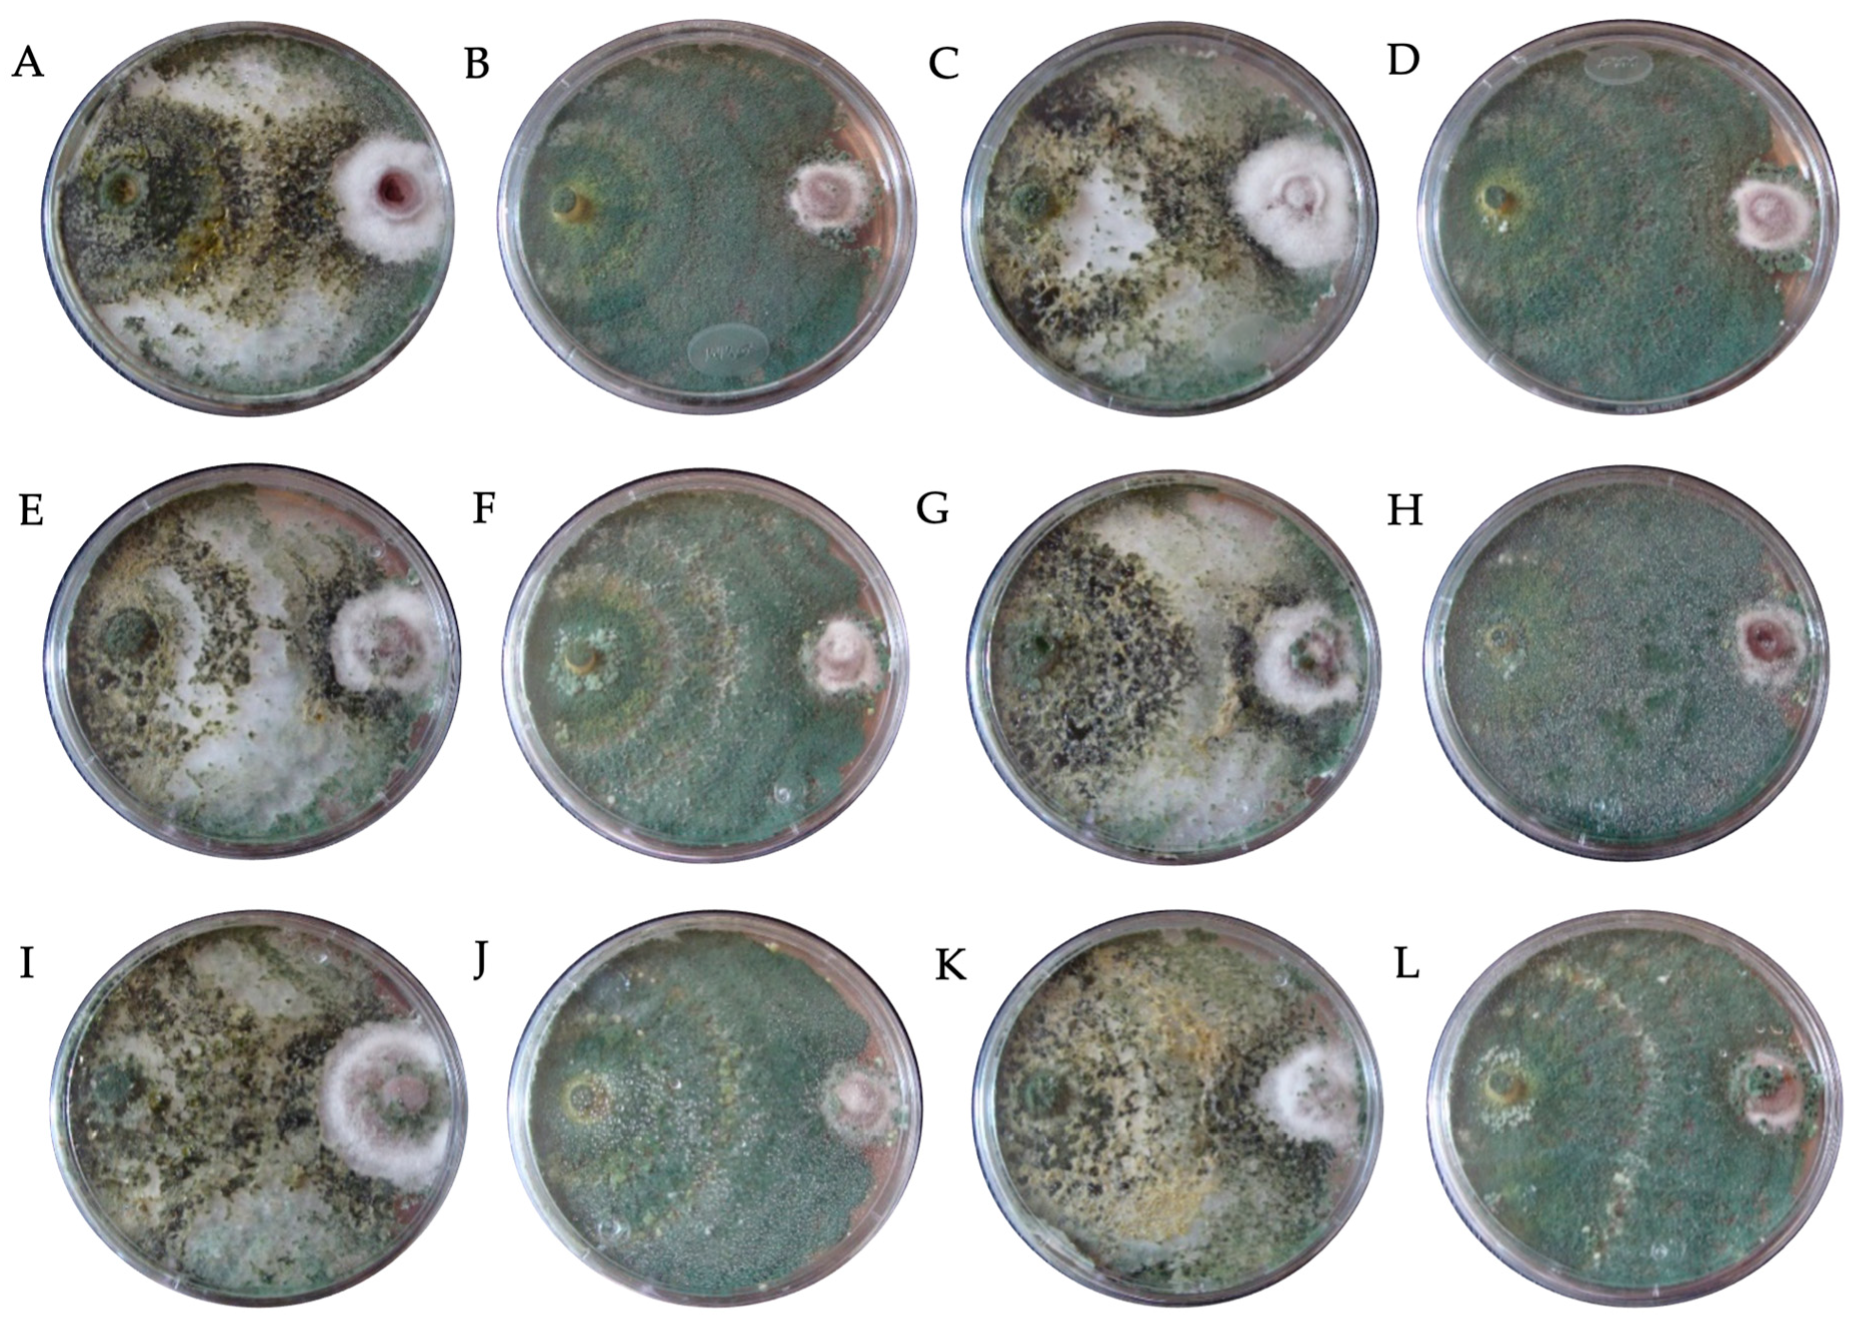
Horticulturae 09 00905 g002 Horticulturae 09 00905 g002
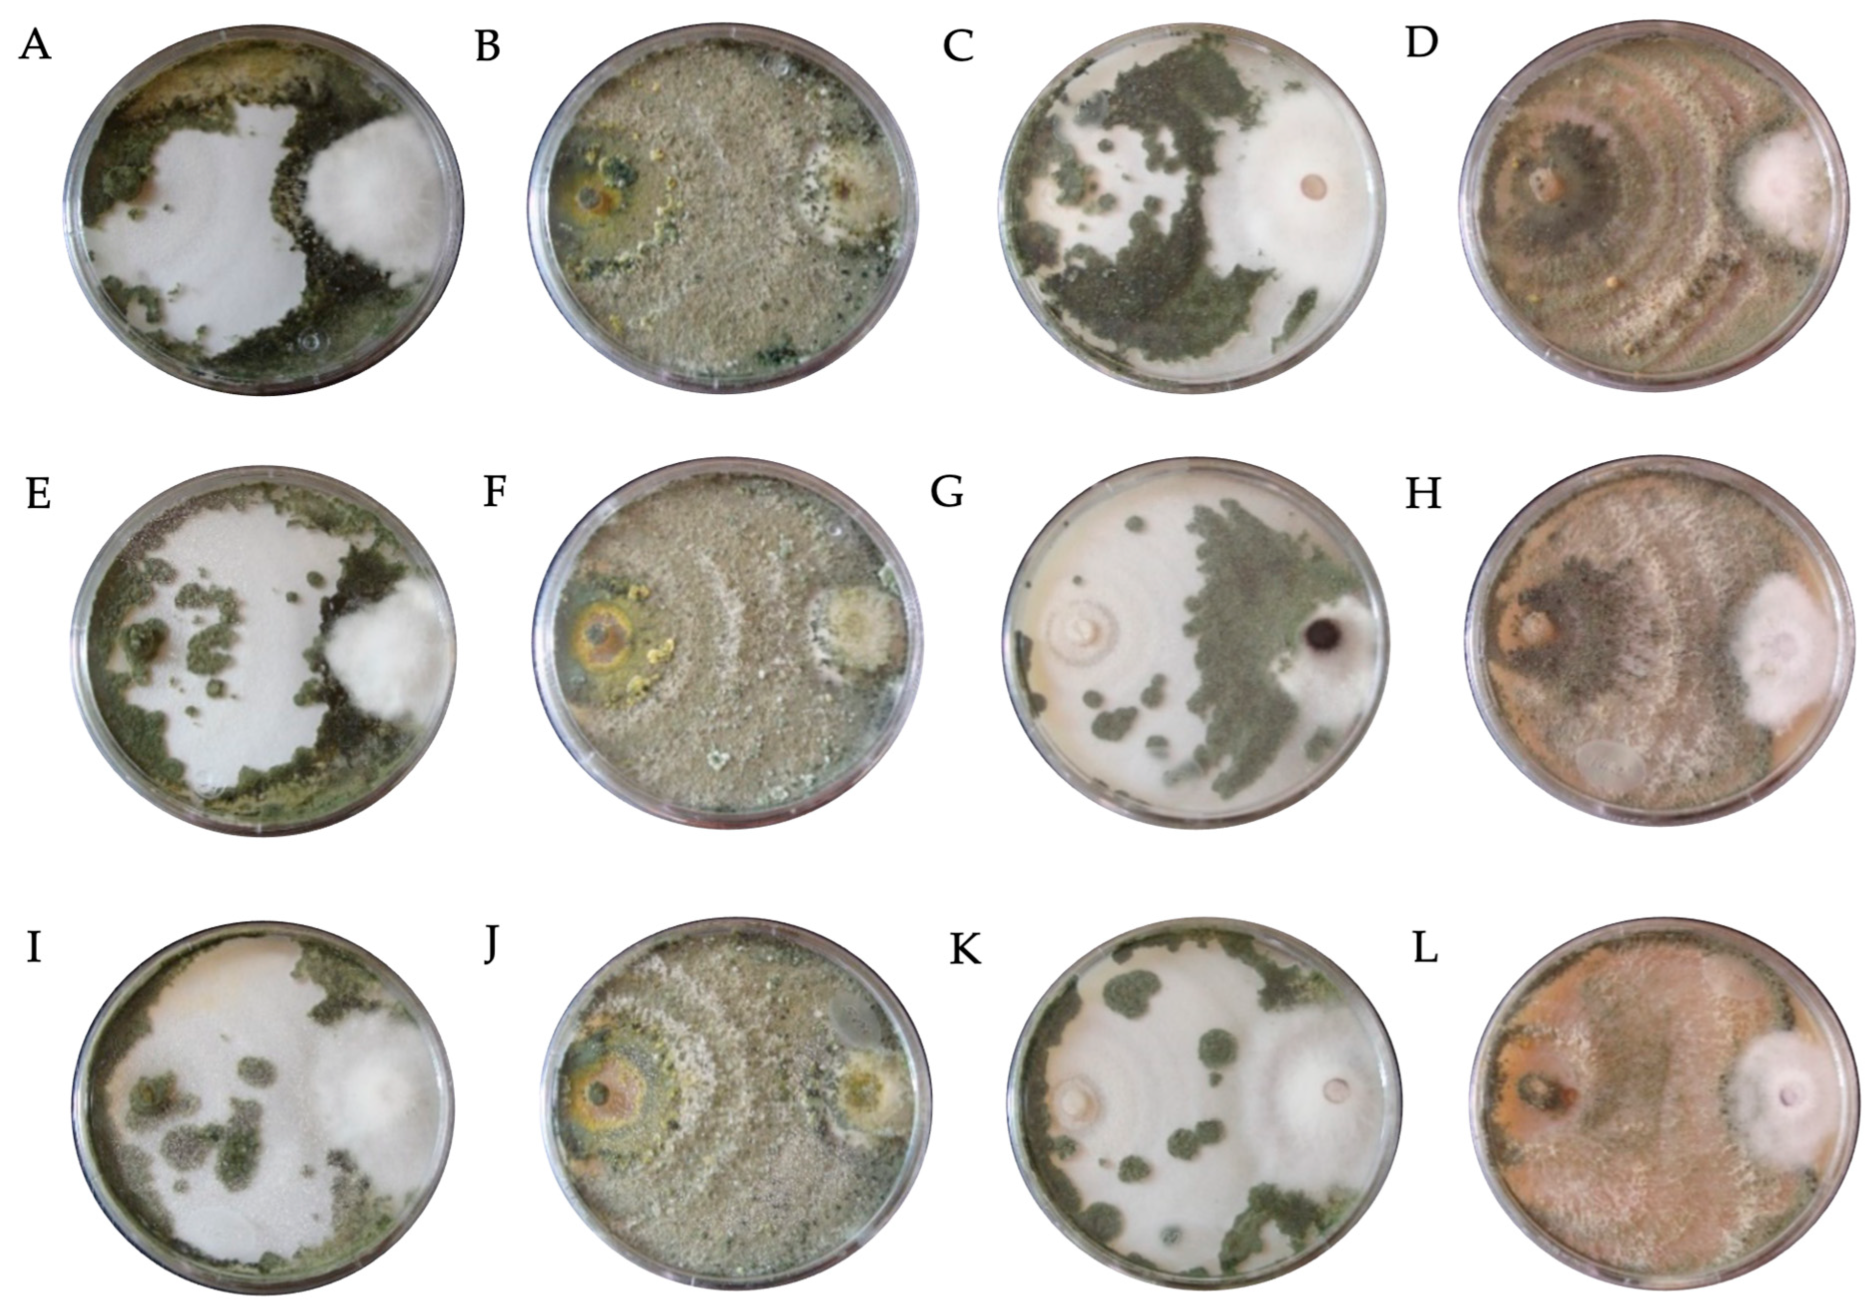
Horticulturae 09 00905 g003 Horticulturae 09 00905 g003
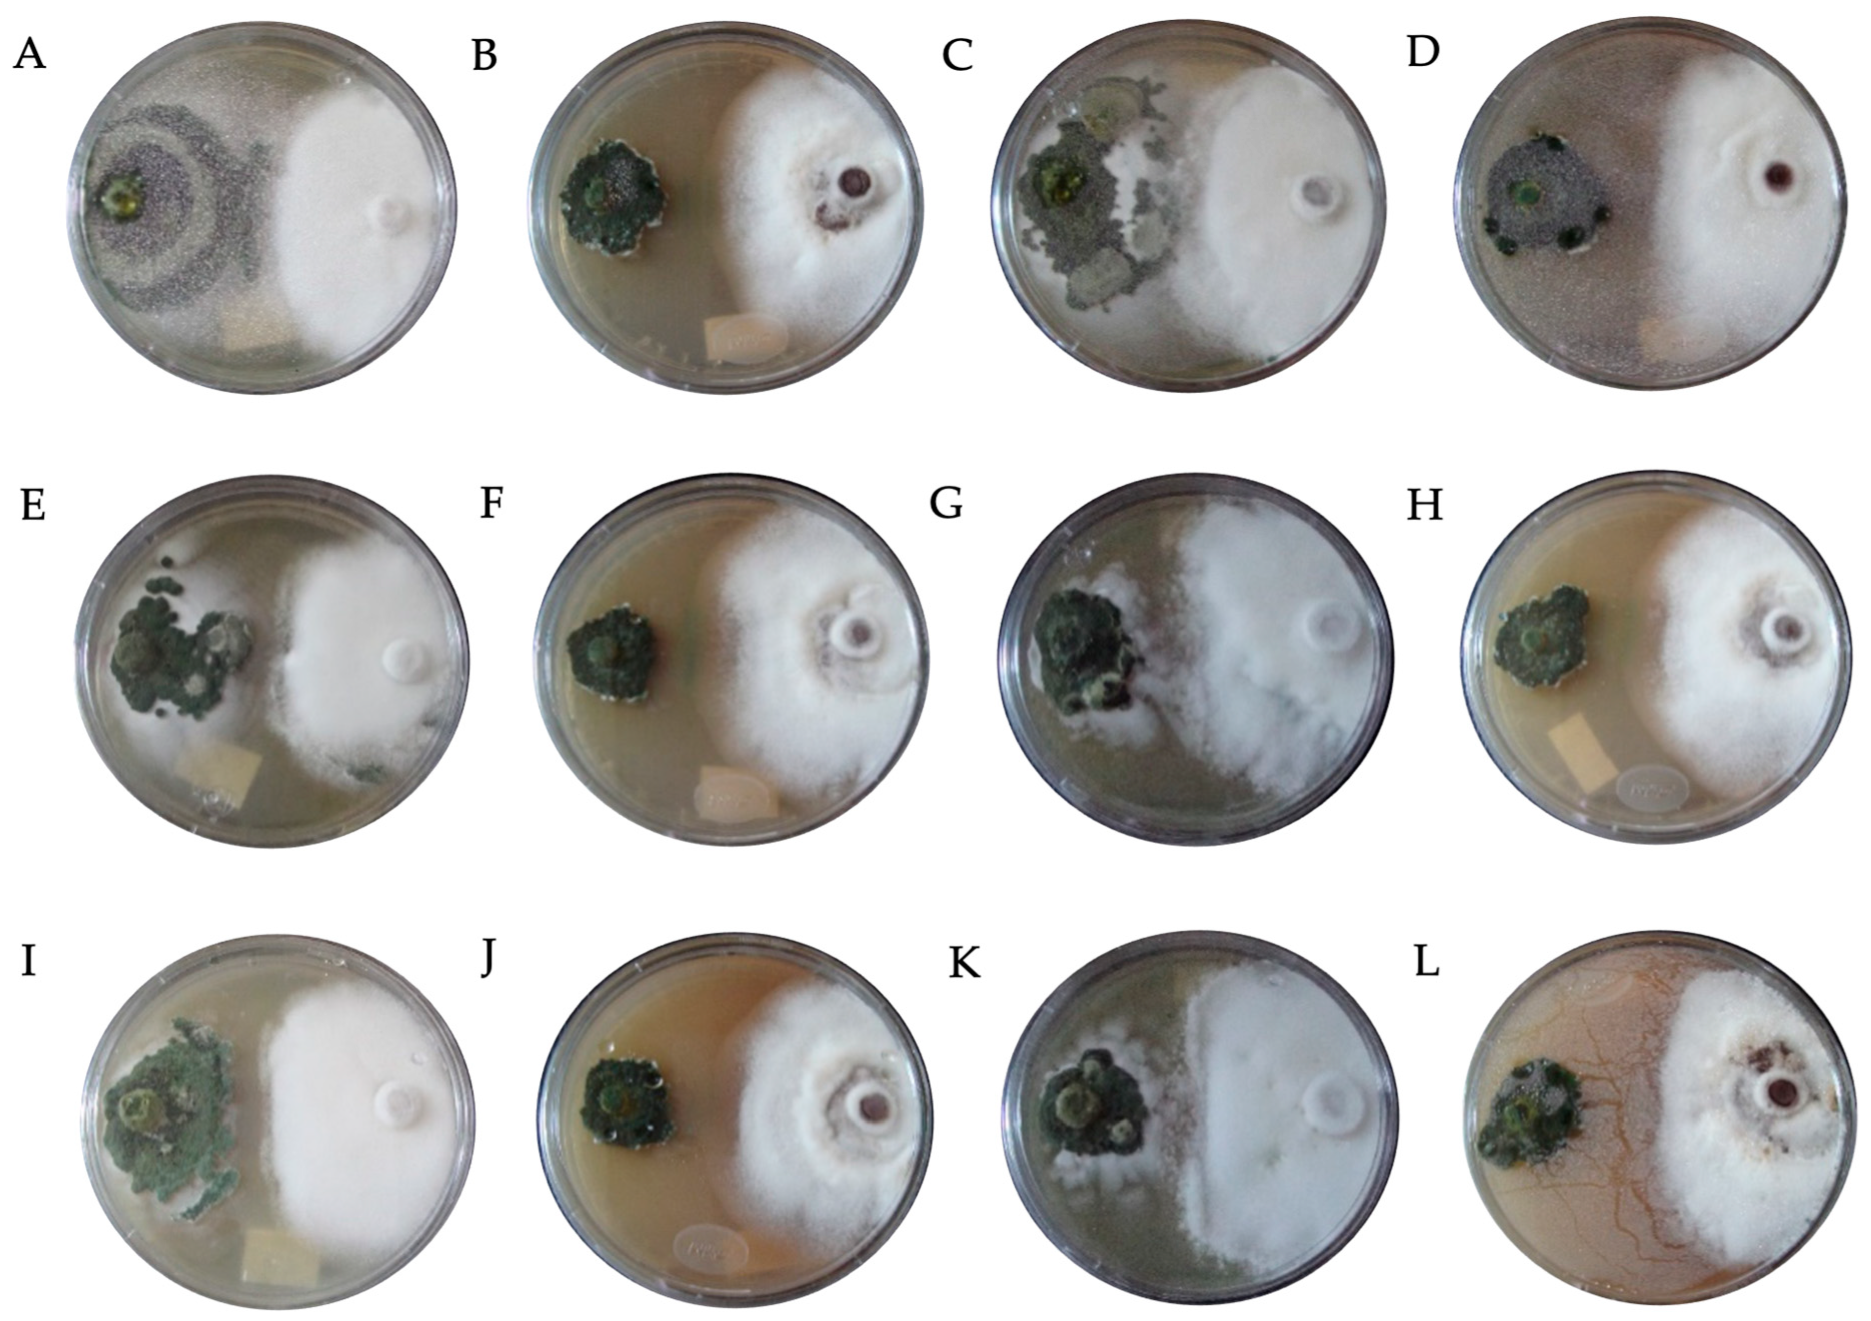
Horticulturae 09 00905 g004 Horticulturae 09 00905 g004

In Vitro Study of the Compatibility of Four Species of Trichoderma with Three Fungicides and Their Antagonistic Activity against Fusarium solani
Abstract
1. Introduction
2. Materials and Methods
2.1. Biological Material
2.2. Characterization of the Rate of Development and Growth
- y = Distance;
- m = Slope;
- x = Time;
- b = Constant factor.
2.3. Dual Test on Poisoned Culture Medium In Vitro
- PIRG = Percentage inhibition of radial growth;
- R1 = Radial growth (mm) of F. solani without Trichoderma spp.;
- R2 = Radial growth (mm) of F. solani with Trichoderma spp.
2.4. Potential Antagonism
- PA = Potential antagonism expressed as a percentage;
- Bell = Trichoderma mycoparasitism against F. solani;
- PIRG = Inhibition of radial growth of F. solani.
2.5. Statistical Analysis
- Cγj = Value of the response variable of the experimental unit associated with the γ-th treatment and the j-th repetition;
- μ = Corresponds to the overall mean of the response variable in the experiment;
- ti = Effect of the γ-th treatment;
- εγj = Error of the experimental unit associated with the γ-th treatment;
- j = The j-th repetition;
- γ = 1, 2, 3, 4, …, 40;
- j = 1, 2, 3, 4;
- C = Compatibility (C%).
3. Results
4. Discussion
5. Conclusions
6. Recommendations
Author Contributions
Funding
Data Availability Statement
Acknowledgments
Conflicts of Interest
References
- Fang, X.L.; Phillips, D.; Li, H.; Sivasithamparam, K.; Barbetti, M.J. Severity of strawberry crown and root diseases and associated fungal and oomycete pathogenesis in Western Australia. Australas Plant Pathol. 2011, 40, 109–119. [Google Scholar] [CrossRef]
- Hassan, O.; Chang, T. Morphological and molecular characteristics of fungal species associated with strawberry crown rot in South Korea. Mol. Biol. Rep. 2022, 49, 51–62. [Google Scholar] [CrossRef] [PubMed]
- Martínez, K.; Ortiz, M.; Albis, A.; Gilma Gutiérrez Castañeda, C.; Valencia, M.E.; Grande Tovar, C.D. The effect of edible chitosan coatings incorporated with Thymus capitatus essential oil on the shelf-life of strawberry (Fragaria x ananassa) during cold storage. Biomolecules 2018, 8, 155. [Google Scholar] [CrossRef] [PubMed]
- Hong, S.; Kim, T.Y.; Won, S.-J.; Moon, J.-H.; Ajuna, H.B.; Kim, K.Y.; Ahn, Y.S. Control of fungal diseases and fruit yield improvement of strawberry using Bacillus velezensis CE 100. Microorganisms 2022, 10, 365. [Google Scholar] [CrossRef] [PubMed]
- Coronel, A.C.; Parraguirre-Lezama, C.; Pacheco-Hernández, Y.; Santiago-Trinidad, O.; Rivera-Tapia, A.; Romero-Arenas, O. Efficacy of four In vitro fungicides for control of wilting of strawberry crops in Puebla-Mexico. Appl. Sci. 2022, 12, 3213. [Google Scholar] [CrossRef]
- Ruiz-Romero, P.; Valdez-Salas, B.; González-Mendoza, D.; Mendez-Trujillo, V. Antifungal effects of silver phyto-nanoparticles from Yucca shilerifera against strawberry soil-borne pathogens: Fusarium solani and Macrophomina phaseolina. Mycobiology 2018, 46, 47–51. [Google Scholar] [CrossRef]
- De la Lastra, E.; Villarino, M.; Astacio, J.D.; Larena, I.; De Cal, A.; Capote, N. Genetic diversity, and vegetative compatibility of Fusarium solani species complex of strawberry in Spain. Phytopathology 2019, 109, 2142–2151. [Google Scholar] [CrossRef]
- Villarino, M.; De la Lastra, E.; Basallote-Ureba, M.J.; Capote, N.; Larena, I.; Melgarejo, P.; De Cal, A. Characterization of Fusarium solani populations associated with Spanish strawberry crops. Plant Dis. 2019, 103, 1974–1982. [Google Scholar] [CrossRef]
- Manici, L.M.; Caputo, F.; Baruzzi, G. Additional experiences to elucidate the microbial component of soil suppressiveness towards strawberry black root rot complex. Ann. App. Biol. 2005, 146, 421–431. [Google Scholar] [CrossRef]
- Ayoubi, N.; Soleimani, M.J. Morphological and molecular identification of pathogenic Fusarium spp. on strawberry in Iran. Sydowia 2016, 68, 163–171. [Google Scholar]
- Ceja-Torres, L.F.; Mora-Aguilera, G.; Téliz, D.; Mora-Aguilera, A.; Sánchez-García, P.; Muñoz-Ruíz, C.; Tlapal-Bolaños, B.; De La Torre-Almaraz, R. Ocurrencia de hongos y etiología de la secadera de la fresa con diferentes sistemas de manejo agronómico. Agrociencia 2008, 42, 451–461. [Google Scholar]
- Zhang, Y.; Yu, H.; Hu, M.; Wu, J.; Zhang, C. Fungal pathogens associated with strawberry crown rot disease in China. J. Fungi 2022, 8, 1161. [Google Scholar] [CrossRef]
- Ons, L.; Bylemans, D.; Thevissen, K.; Cammue, B.P.A. Combining Biocontrol Agents with Chemical Fungicides for Integrated Plant Fungal Disease Control. Microorganisms 2020, 8, 1930. [Google Scholar] [CrossRef]
- Sood, M.; Kapoor, D.; Kumar, V.; Sheteiwy, M.S.; Ramakrishnan, M.; Landi, M.; Araniti, F.; Sharma, A. Trichoderma: The “Secrets” of a Multitalented Biocontrol Agent. Plants 2020, 9, 762. [Google Scholar] [CrossRef]
- James, J.E.; Santhanam, J.; Cannon, R.D.; Lamps, E. Voriconazole treatment induces a conserved regulatory network of sterol/pleiotropic drug resistance, including an alternative pathway of ergosterol biosynthesis, in the clinically important FSSC species, Fusarium keratoplasticum. J. Fungi 2022, 8, 1070. [Google Scholar] [CrossRef]
- Slaboch, J.; Čechura, L.; Malý, M.; Mach, J. The Shadow Values of Soil Hydrological Properties in the Production Potential of Climatic Regionalization of the Czech Republic. Agriculture 2022, 12, 2068. [Google Scholar] [CrossRef]
- Zhang, C.; Wang, W.; Xue, M.; Liu, Z.; Zhang, Q.; Hou, J.; Xing, M.; Wang, R.; Liu, T. The combination of a biocontrol agent Trichoderma asperellum SC012 and hymexazol reduces the effective fungicide dose to control Fusarium Wilt in Cowpea. J. Fungi 2021, 7, 685. [Google Scholar] [CrossRef] [PubMed]
- Rabølle, M.; Spliid, N.H.; Kristensen, K.; Kudsk, P. Determination of fungicide residues in field-grown strawberries following different fungicide strategies against gray mold (Botrytis cinerea). J. Agric. Food Chem. 2006, 54, 900–908. [Google Scholar] [CrossRef] [PubMed]
- Mayo-Prieto, S.; Squarzoni, A.; Carro-Huerga, G.; Porteous-Álvarez, A.J.; Gutiérrez, S.; Casquero, P.A. Organic and conventional bean pesticides in the development of autochthonous strains of Trichoderma. J. Fungi 2022, 8, 603. [Google Scholar] [CrossRef]
- Omar, I.; O’neill, T.M.; Rossall, S. Biological control of Fusarium crown and root rot of tomato with antagonistic bacteria and integrated control when combined with the fungicide carbendazim. Plant Pathol. 2006, 55, 92–99. [Google Scholar] [CrossRef]
- Spadaro, D.; Gullino, M.L. State of the art and future prospects of the biological control of postharvest fruit diseases. Int. J. Food Microbiol. 2004, 91, 185–194. [Google Scholar] [CrossRef]
- Wisniewski, M.E.; Wilson, C.L.; Hershherger, W. Characterization of inhibition of Rhizopus stolonifer germination and growth by Enterobacter cloacae. Can. J. Bot. 1989, 67, 2317–2323. [Google Scholar] [CrossRef]
- Abd-El-Khair, H.; Elshahawy, I.E.; Haggag, H.E. Field application of Trichoderma spp. combined with thiophanate-methyl for controlling Fusarium solani and Fusarium oxysporum in dry bean. Bull. Natl. Res. Cent. 2019, 43, 1–9. [Google Scholar] [CrossRef]
- Terrero-Yépez, P.I.; Peñaherrera-Villafuerte, S.L.; Solís-Hidalgo, Z.K.; Vera-Coello, D.I.; Navarret- Cedeño, J.B.; Herrera-Defaz, M.A. Compatibilidad in vitro de Trichoderma spp. con fungicidas de uso común en cacao (Theobroma cacao L.). Investig. Agrar. 2018, 20, 146–151. [Google Scholar] [CrossRef]
- Ruano-Rosa, D.; Arjona-Girona, I.; López-Herrera, C.J. Integrated control of avocado white root rot combining low concentrations of fluazinam and Trichoderma spp. Crop Prot. 2018, 112, 363–370. [Google Scholar] [CrossRef]
- Wang, H.; Chang, K.F.; Hwang, S.F.; Turnbull, G.D.; Howard, R.J.; Blade, S.F.; Callan, N.W. Fusarium root rot of coneflower seedlings and integrated control using Trichoderma and fungicides. BioControl 2005, 50, 317–329. [Google Scholar] [CrossRef]
- Zeravakis, G.; Philippoussis, A.; Ioannidou, S.; Diamantopoulou, P. Mycelium growth kinetics and optimal temperature conditions for the cultivation of edible mushroom species on lignocellulosic substrates. Folia Microbiol. 2001, 46, 231–234. [Google Scholar] [CrossRef]
- Azza, R.E.; Hala, M.I.; Saná, A.M. The role of storage in Mancozeb fungicidal formulations and its antifungal activity against Fusarium oxysporium and Rhizoctonia solani. Árab. J. Chem. 2021, 14, 103322. [Google Scholar] [CrossRef]
- Andrade-Hoyos, P.; Luna-Cruz, L.; Osorio-Hernández, E.; Molina-Gayosso, E.; Landero-Valenzuela, N.; Barrales-Cureño, H.J. Antagonismo de Trichoderma spp. vs. Hongos Asociados a la Marchitez de Chile. Rev. Mex. Cienc. Agric. 2019, 10, 1259–1272. [Google Scholar] [CrossRef]
- Bell, D.K.; Wells, H.D.; Markham, C.R. In vitro antagonism of Trichoderma species against six fungal plant pathogens. Phytopathology 1982, 72, 379–382. [Google Scholar] [CrossRef]
- Reyes-Figueroa, O.; Ortiz-García, C.F.; Torres de la Cruz, M.; Lagunes-Espinoza, L.D.C.; Valdovinos-Ponce, G. Especies de Trichoderma del agroecosistema cacao con potencial de biocontrol sobre Moniliophthora roreri. Chapingo Ser. Cienc. Ambiente 2016, 22, 149–163. [Google Scholar] [CrossRef]
- De Mendiburu, F.; Simon, R. Agricolae-Ten years of an open-source statistical tool for experiments in breeding, agriculture and biology. Peer J. PrePrints 2015, 3, e1404v1. [Google Scholar] [CrossRef]
- Yan, K.; Han, G.; Ren, C.; Zhao, S.; Wu, X.; Bian, T. Fusarium solani infection depressed photosystem performance by inducing foliage wilting in apple seedlings. Front. Plant Sci. 2018, 9, 479. [Google Scholar] [CrossRef]
- Gu, K.X.; Canción, X.S.; Xiao, X.M.; Duan, X.X.; Wang, J.X.; Duan, Y.B.; Hou, Y.P.; Zhou, M.G. A β2-tubulin dsRNA derived from Fusarium asiaticum confers plant resistance to multiple phytopathogens and reduces fungicide resistance. Pestic. Biochem. Physiol. 2019, 153, 36–46. [Google Scholar] [CrossRef]
- Essa, T. Response of some commercial strawberry cultivars to infection by wilt diseases in Egypt and their control with fungicides. Egypt. J. Pathol. 2015, 43, 113–127. [Google Scholar] [CrossRef]
- Robledo-Buriticá, J.; Ángel-García, C.; Castaño-Zapata, J. Microscopía electrónica de barrido ambiental del proceso de infección de Fusarium solani f. sp. passiflorae en plántulas de maracuyá (Passiflora edulis f. flavicarpa). Rev. Acad. Cienc. Exactas 2017, 41, 213–221. [Google Scholar]
- Morales-Mora, L.A.; Andrade-Hoyos, P.; Valencia-de Ita, M.A.; Romero-Arenas, O.; Silva-Rojas, H.V.; Contreras-Paredes, C.A. Caracterización de hongos asociados a fresa y efecto antagonista in vitro de Trichoderma harzianum. Rev. Mex. Fitopatol. 2020, 38, 434–449. [Google Scholar] [CrossRef]
- Miguel-Ferrer, L.; Romero-Arenas, O.; Andrade-Hoyos, P.; Sánchez-Morales, P.; Rivera-Tapia, J.A.; Fernández-Pavía, S.P. Antifungal activity of Trichoderma harzianum and T. koningiopsis against Fusarium solani in seed germination and vigor of Miahuateco chili seedlings. Rev. Mex. Fitopatol. 2021, 39, 228–247. [Google Scholar] [CrossRef]
- Guigón-López, C.; Guerrero-Prieto, V.; Vargas-Albores, F.; Carvajal-Millán, E.; Ávila-Quezada, G.D.; Bravo-Luna, L.; Ruocco, M.; Lanzuise, S.; Woo, S.; Lorito, M. Identificación molecular de cepas nativas de Trichoderma spp. su tasa de crecimiento in vitro y antagonismo contra hongos fitopaógenos. Rev. Mex. Fitopatol. 2010, 28, 87–96. [Google Scholar]
- Suárez, C.; Fernández, R.; Valero, N.; Gámez, R.; Páez, A. Antagonismo in vitro de Trichoderma harzianum Rifai sobre Fusarium solani (Mart.) Sacc., asociado a la marchitezen maracuyá. Rev. Colomb. Biotecnol. 2008, 2, 35–43. [Google Scholar] [CrossRef]
- Michel-Aceves, A.C.; Otero-Sánchez, M.A.; Rebolledo-Domínguez, O.; Lezama-Gutiérrez, R.; Ariza-Flores, R.; Barrios-Ayala, A. Producción y efecto antagónico de quitinasas y glucanasas por Trichoderma spp. en la inhibiciónde Fusarium subglutinans y Fusarium oxysporum in vitro. Rev. Chapingo Ser. Hortic. 2005, 11, 273–278. [Google Scholar] [CrossRef]
- Manzar, N.; Kashyap, A.S.; Goutam, R.S.; Rajawat, M.V.S.; Sharma, P.K.; Sharma, S.K.; Singh, H.V. Trichoderma: Advent of Versatile Biocontrol Agent, Its Secrets and Insights into Mechanism of Biocontrol Potential. Sustainability 2022, 14, 12786. [Google Scholar] [CrossRef]
- Peláez-Álvarez, A.; Santos-Villalobos, S.D.L.; Yépez, E.A.; Parra-Cota, F.I.; Reyes-Rodríguez, R.T. Synergistic effect of Trichoderma asperelleum T8A and Captan against Colletotrichum gloeosporioides (Penz.). Rev. Mex. Cienc. Agric. 2016, 7, 1401–1412. [Google Scholar]
- Ruocco, M.; Lanzuise, S.; Vinale, F.; Marra, R.; Turrà, D.; Woo, S.L.; Lorito, M. Identification of a new biocontrol gene in Trichoderma atroviride: The role of anABC transporter membrane pump in the interaction with different plant-pathogenic fungi. Mol. Plant-Microbe Interact. 2009, 22, 291–301. [Google Scholar] [CrossRef] [PubMed]
- Singh, G.; Varma, R.K. Compatibility of fungicides and neem products against Fusariu solani f.sp. glycines causing root rot of soybean and Trichoderma spp. J. Mycopathol. Res. 2005, 43, 211–214. [Google Scholar]
- Gonzalez, M.F.; Magdama, F.; Galarza, L.; Sosa, D.; Romero, C. Evaluation of the sensitivity and synergistic effect of Trichoderma reesei and Mancozeb to inhibit under in vitro conditions the growth of Fusarium oxysporum. Commun. Integr. Biol. 2020, 13, 160–169. [Google Scholar] [CrossRef]
- Huilgol, S.N.; Pratibha, M.P.; Hegde, G.M.; Banu, H. Evaluation, and compatibility of new fungicides with Trichoderma harzianum for managing the charcoal rot of soybean. Pharma Innov. J. 2022, 11, 659–664. [Google Scholar]
- Maheshwary, N.; Gangadhara-Naik, B.; Amoghavarsha-Chittaragi, M.; Naik, S.K.; Nandish, M. Compatibility of Trichoderma asperellum with fungicides. Pharma Innov. J. 2020, 9, 136–140. [Google Scholar]
- Hirpara, D.G.; Gajera, H.P. Molecular heterozygosity and genetic exploitations of Trichoderma interfusants enhancing tolerance to fungicides and mycoparasitism against Sclerotium rolfsii Sacc. Infect. Genet. Evol. 2018, 66, 26–36. [Google Scholar] [CrossRef]
- Sun, J.; Zhang, T.; Li, Y.; Wang, X.; Chen, J. Functional characterization of the ABC transporter TaPdr2 in the tolerance of biocontrol the fungus Trichoderma atroviride T23 to dichlorvos stress. Biological. Control 2019, 129, 102–108. [Google Scholar] [CrossRef]
- Hu, X.; Roberts, D.P.; Xie, L.; Yu, C.; Li, Y.; Qin, L.; Liao, X. Use of formulated Trichoderma sp. Tri-1 in combination with reduced rates of chemical pesticide for control of Sclerotinia sclerotiorium on oilseed rape. Crop Prot. 2016, 79, 124–127. [Google Scholar] [CrossRef]
- Elshahawy, I.E.; Haggag, K.H.E.; Abd-El-Khaira, H. Compatibility of Trichoderma spp. with seven chemical fungicides used in the control of soil borne plant pathogens. Res. J. Pharm. Biol. Chem. Sci. 2016, 7, 1772–1785. [Google Scholar]
- Gangopadhyay, S.; Gopal, R.; Godara, S.L. Effect of Fungicides and antagonists on Fusarium wilt of Cumin. J. Mycol. Plant Pathol. 2009, 39, 331–334. [Google Scholar]
- Monadjemi, S.; El Roz, M.; Richard, C.; Ter Halle, A. Photoreduction of Chlorothalonil fungicide in plant leaf models. Entorno Sci. Technol. 2011, 45, 9582–9589. [Google Scholar] [CrossRef]
- National Center for Biotechnology Information. Available online: https://pubchem.ncbi.nlm.nih.gov/compound/Chlorothalonil (accessed on 12 April 2023).

| Fungicide (Tradename) | Active Ingredient | Molecular Formula | Concentration (mg L−1) | ||
|---|---|---|---|---|---|
| Low | Recommended | High | |||
| Control | Water | H2O | - | - | - |
| Captan 50® | Captan | C9H8Cl3NO2S | 450 | 900 | 1350 |
| Mancosol 80® | Mancozeb | C4H6MnN2S4 | |||
| Talonil 75® | Chlorothalonil | C8Cl4N2 | |||
| Class | Mycoparasitism (%) | Characteristics |
|---|---|---|
| I | 100 | Trichoderma grew completely over F. solani and covered the entire mid-surface. |
| II | 75 | Trichoderma grew over at least two-thirds of the mid-surface. |
| III | 50 | Trichoderma and F. solani colonized approximately half of the mid-surface. |
| IV | 25 | F. solani colonized at least two-thirds of the mid-surface. |
| V | 0 | F. solani grew completely over Trichoderma and occupied the entire mid-surface. |
| Grade | Ranges (%) | Compatibility |
|---|---|---|
| I | 23 to 42 | Null |
| II | 43 to 59 | Low |
| III | 60 to 75 | Medium |
| IV | 76 to 93 | High |
| Code | Species | Strains | * Development Rate (mm h−1) | * Growth Rate (cm d−1) |
|---|---|---|---|---|
| DTF0 | F. solani | MA-FC120 | 0.28 ± 0.08 e | 6.71 ± 0.08 e |
| DTH0 | T. hamatum | T-A12 | 1.02 ± 0.02 d | 26.19 ± 0.53 b |
| DTA0 | T. asperellum | T-AS1 | 1.07 ± 0.05 c | 24.92 ± 1.34 d |
| DTK0 | T. konigiopsis | T-K11 | 1.17 ± 0.02 a | 26.82 ± 0.6 a |
| DTHR0 | T. harzianum | T-H4 | 1.14 ± 0.5 b | 25.20 ± 0.02 c |
| Code | Fungicide | Concentration (mg L−1) | Species | * PIRG (%) | SE | Bell Scale |
|---|---|---|---|---|---|---|
| DTH0 | Control (PDA) | - | T. hamatum | 66.95 bcde ± 0.34 | II | |
| DTA0 | T. asperellum | 66.91 bcde ± 0.26 | II | |||
| DTK0 | T. konigiopsis | 64.34 def ± 0.59 | II | |||
| DTHR0 | T. harzianum | 67.31 bcde ± 1.16 | II | |||
| DTH1 | Captan | 450 | T. hamatum | 71.11 bcde ± 1.63 | II | |
| DTA1 | T. asperellum | 76.33 a ± 1.16 | I | |||
| DTK1 | T. konigiopsis | 67.37 bcde ± 1.31 | II | |||
| DTHR1 | T. harzianum | 74.82 b ± 1.01 | I | |||
| DTH2 | 900 | T. hamatum | 69.19 bcde ± 3.16 | II | ||
| DTA2 | T. asperellum | 73.68 bc ± 1.34 | I | |||
| DTK2 | T. konigiopsis | 66.30 bcde ± 0.32 | II | |||
| DTHR2 | T. harzianum | 74.58 b ± 1.11 | I | |||
| DTH3 | 1350 | T. hamatum | 68.37 bcde ± 2.19 | II | ||
| DTA3 | T. asperellum | 72.84 bcd ± 1.08 | I | |||
| DTK3 | T. konigiopsis | 64.84 cde ± 2.32 | II | |||
| DTHR3 | T. harzianum | 72.15 bcd ± 2.51 | I | |||
| DTH4 | Mancozeb | 450 | T. hamatum | 67.96 bcde ± 0.85 | II | |
| DTA4 | T. asperellum | 68.56 bcde ± 1.40 | I | |||
| DTK4 | T. konigiopsis | 64.76 cde ± 1.09 | II | |||
| DTHR4 | T. harzianum | 69.60 bcde ± 1.27 | II | |||
| DTH5 | 900 | T. hamatum | 65.88 bcde ± 1.00 | II | ||
| DTA5 | T. asperellum | 67.93 bcde ± 1.14 | I | |||
| DTK5 | T. konigiopsis | 62.82 efg ± 0.82 | II | |||
| DTHR5 | T. harzianum | 68.21 bcde ± 1.80 | II | |||
| DTH6 | 1350 | T. hamatum | 65.72 bcde ± 0.82 | II | ||
| DTA6 | T. asperellum | 66.16 bcde ± 0.91 | I | |||
| DTK6 | T. konigiopsis | 62.47 efg ± 0.15 | II | |||
| DTHR6 | T. harzianum | 67.29 bcde ± 0.60 | II | |||
| DTH7 | Chlorothalonil | 450 | T. hamatum | 49.52 h ± 1.22 | III | |
| DTA7 | T. asperellum | 28.71 i ± 2.24 | IV | |||
| DTK7 | T. konigiopsis | 55.38 fgh ± 1.88 | III | |||
| DTHR7 | T. harzianum | 46.33 h ± 2.36 | III | |||
| DTH8 | 900 | T. hamatum | 48.38 h ± 0.68 | III | ||
| DTA8 | T. asperellum | 28.62 i ± 2.94 | IV | |||
| DTK8 | T. konigiopsis | 50.91 gh ± 1.96 | III | |||
| DTHR8 | T. harzianum | 28.15 i ± 1.83 | IV | |||
| DTH9 | 1350 | T. hamatum | 48.05 h ± 3.65 | III | ||
| DTA9 | T. asperellum | 24.35 i ± 0.97 | IV | |||
| DTK9 | T. konigiopsis | 49.62 h ± 1.26 | III | |||
| DTHR9 | T. harzianum | 26.72 i ± 1.19 | IV | |||
| Origin | Dependent Variable | Sum of Squares (Type III) | gL | Mean Square | F | Sig. |
|---|---|---|---|---|---|---|
| Corrected mode | X1 = PIRG | 27,481.902 a | 39 | 704.664 | 64.55 | <0.001 |
| X2 = Bell | 64,000.000 b | 39 | 1641.026 | 157.538 | <0.001 | |
| X3 = PA | 41,743.713 c | 39 | 1070.352 | 204.495 | <0.001 | |
| Intersection | X1 | 589,547.5 | 1 | 589,547.5 | 54,004.82 | <0.001 |
| X2 | 702,250 | 1 | 702,250 | 67,416 | <0.001 | |
| X3 | 644,671.1 | 1 | 644,671.1 | 123,166.8 | <0.001 | |
| Compatibility (C%) | X1 | 27,481.9 | 39 | 704.664 | 64.55 | <0.001 |
| X2 | 64,000 | 39 | 1641.026 | 157.538 | <0.001 | |
| X3 | 41,743.71 | 39 | 1070.352 | 204.495 | <0.001 | |
| Error | X1 | 1309.989 | 120 | 10.917 | ||
| X2 | 1250 | 120 | 10.417 | |||
| X3 | 628.095 | 120 | 5.234 | |||
| Total | X1 | 618,339.4 | 160 | |||
| X2 | 767,500 | 160 | ||||
| X3 | 687,043 | 160 | ||||
| Total corrected | X1 | 28,791.89 | 159 | |||
| X2 | 65,250 | 159 | ||||
| X3 | 42,371.81 | 159 |
Disclaimer/Publisher’s Note: The statements, opinions and data contained in all publications are solely those of the individual author(s) and contributor(s) and not of MDPI and/or the editor(s). MDPI and/or the editor(s) disclaim responsibility for any injury to people or property resulting from any ideas, methods, instructions or products referred to in the content. |
© 2023 by the authors. Licensee MDPI, Basel, Switzerland. This article is an open access article distributed under the terms and conditions of the Creative Commons Attribution (CC BY) license (https://creativecommons.org/licenses/by/4.0/).
Share and Cite
Parraguirre Lezama, C.; Romero-Arenas, O.; Valencia de Ita, M.D.L.A.; Rivera, A.; Sangerman Jarquín, D.M.; Huerta-Lara, M. In Vitro Study of the Compatibility of Four Species of Trichoderma with Three Fungicides and Their Antagonistic Activity against Fusarium solani. Horticulturae 2023, 9, 905. https://doi.org/10.3390/horticulturae9080905
Parraguirre Lezama C, Romero-Arenas O, Valencia de Ita MDLA, Rivera A, Sangerman Jarquín DM, Huerta-Lara M. In Vitro Study of the Compatibility of Four Species of Trichoderma with Three Fungicides and Their Antagonistic Activity against Fusarium solani. Horticulturae. 2023; 9(8):905. https://doi.org/10.3390/horticulturae9080905
Chicago/Turabian StyleParraguirre Lezama, Conrado, Omar Romero-Arenas, Maria De Los Angeles Valencia de Ita, Antonio Rivera, Dora M. Sangerman Jarquín, and Manuel Huerta-Lara. 2023. "In Vitro Study of the Compatibility of Four Species of Trichoderma with Three Fungicides and Their Antagonistic Activity against Fusarium solani" Horticulturae 9, no. 8: 905. https://doi.org/10.3390/horticulturae9080905
APA StyleParraguirre Lezama, C., Romero-Arenas, O., Valencia de Ita, M. D. L. A., Rivera, A., Sangerman Jarquín, D. M., & Huerta-Lara, M. (2023). In Vitro Study of the Compatibility of Four Species of Trichoderma with Three Fungicides and Their Antagonistic Activity against Fusarium solani. Horticulturae, 9(8), 905. https://doi.org/10.3390/horticulturae9080905

